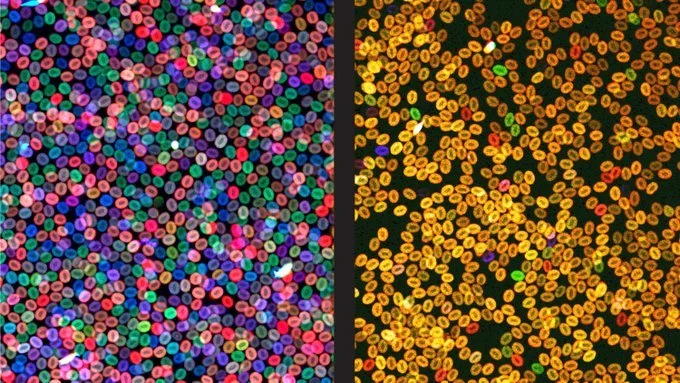

Human Hematopoietic Genetics
Our goal is to understand how genetic variation alters human blood and immune cell production, or hematopoiesis, in health and disease.
Stories from the Lab
-
![A bone marrow specimen from a patient with acute myeloid leukemia.CDC]()
STAT: Genetic variant appears to protect some people against certain blood cancers
Study reveals a potential path to develop therapies for a pre-cancerous condition called CHIP.
-
![]()
U.S. News Best Leaders 2025
Vijay Sankaran selected by U.S. News & World Report as one of the Best Leaders of 2025.
-
![]()
New research paves the way to a better understanding of telomeres
Unraveling the genetics of telomere disease.
-
![]()
Precision reverse-engineering of genetic programming in cells
Perturb-multiome enables an understanding of how transcription factors determine which genetic programs drive blood cell maturation.
-
![]()
The first CRISPR medicine for sickle cell disease
Stuart Orkin, Vijay Sankaran, and David Altshuler share the story of CASGEVY, an FDA-approved therapy, that promises to have a monumental impact on sickle cell disease patients.
-
A universal gene therapy for Diamond-Blackfan anemia is poised for clinical testing
Preclinical research sets the stage for a universal gene therapy for DBA, regardless of the mutation. The key: GATA1.
-
Ancient DNA reveals origin of racial/ethnic disparity in a childhood cancer
A genetic variant with Indigenous American ancestral origins may explain why more Hispanic/Latino children are diagnosed with acute lymphoblastic leukemia.
-
![blood cell tree]()
STAT: New tool for tracing blood cells’ ancestry might one day help predict disease risk
Researchers have developed a way to monitor changes in human blood cells in real time, raising hopes it might one day predict disease risk before symptoms arise.
-
![]()
Researchers use base editing to probe blood cell biology
By editing individual DNA “letters” in blood cells, scientists better understand the molecular underpinnings of some genetic diseases.
-
![Electron microscopy image of a human hematopoietic stem cell showing hallmarks of ferroptosis, including shrunken mitochondria with fewer inner membrane folds.]()
Blood stem cells are susceptible to ferroptosis, a type of cell death
A study of a rare bone marrow disorder reveals that even healthy stem cells are vulnerable to iron-induced cell death.
-
![Lynn Aureli, an oncology nurse with AML]()
How a leukemia hijacks the genes needed by blood stem cells
The genetic changes found in Lynn’s type of leukemia have helped researchers determine what the genes controlled by MECOM do and how those genes affect stem cell function.
-
![Biden giving a presentation about Cancer Moonshot]()
Boston Globe Op-Ed: Can we prevent childhood cancer?
A focus on understanding the root causes of childhood cancers more deeply would have far-reaching implications.
-
![sickle cell disease illustration]()
Sickle cell disease, gene therapy, and blood cancers: Mysteries remain
Could clonal hematopoiesis explain the reports of blood malignancies in patients undergoing sickle cell gene therapy?
-
![]()
New York Times: Stamping barcodes on cells to solve medical mysteries
A new technique called cell barcoding is giving researchers “a view of cancer that we never had before,” says Dr. Sankaran.
-
![Lindsay, who has Diamond-Blackfan Anemia, with her husband]()
Fast tracking a novel DBA gene therapy
The lack of a cure or sustainable long-term solution for those with Diamond-Blackfan anemia, like Lindsay, inspired the Sankaran Lab to experiment with potential treatments.
-
![Meredith as MPN]()
Probing a blood cancer’s genetic origins
When Meredith's headaches turn out to be caused by a rare blood cancer, the Sankaran Lab sets out to untangle the complicated genetics of myeloproliferative neoplasms.
-
![Lamarcus, who has sickle cell disease]()
Decoding sickle cell disease
A recent Sankaran Lab study, which reveals how the fetal to adult hemoglobin switch is regulated, may open new possibilities for sickle cell patients.